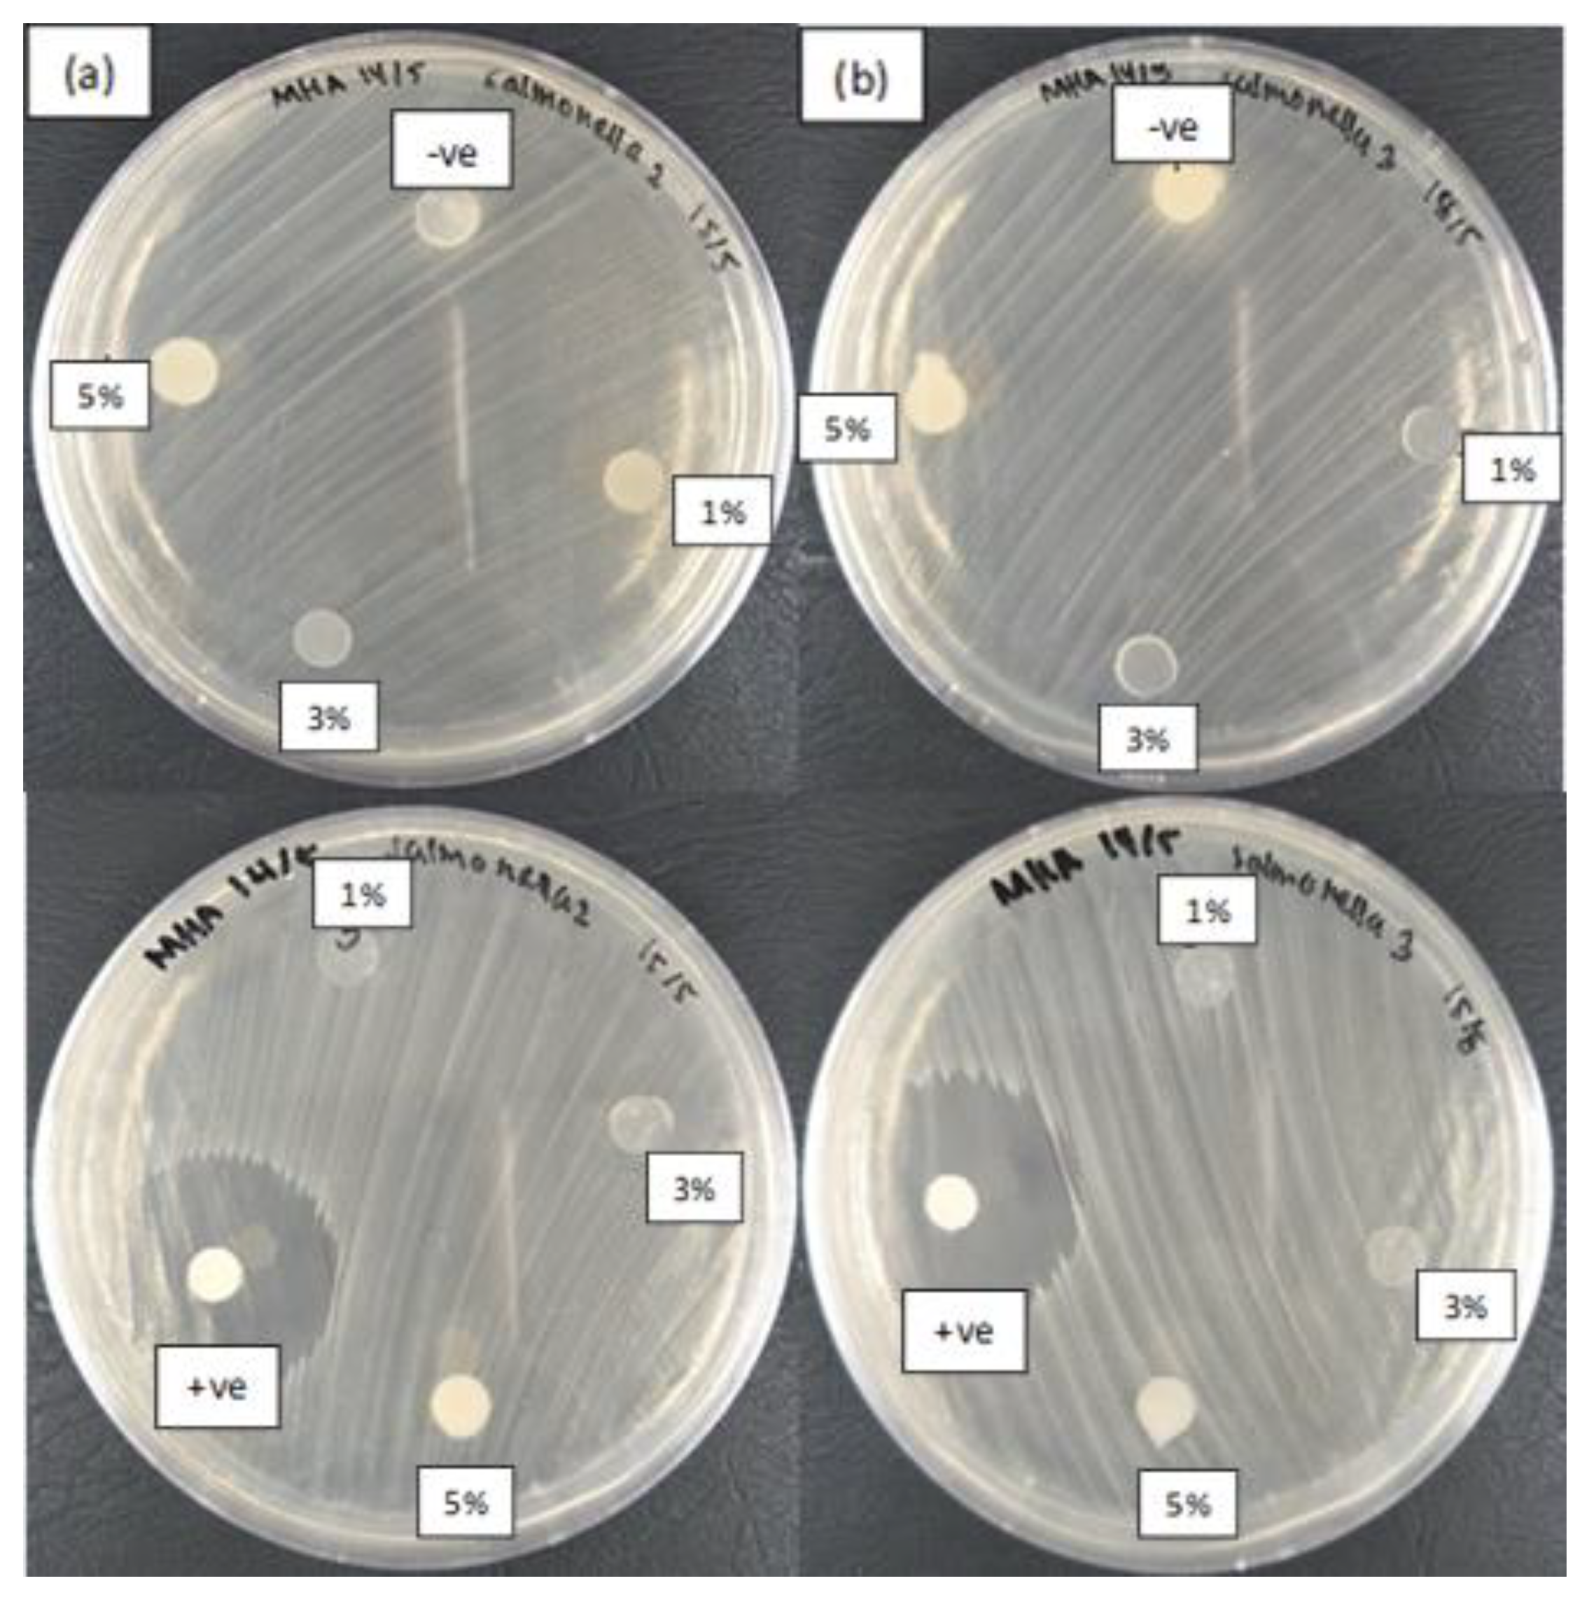
Nanomaterials 10 01061 g008 Nanomaterials 10 01061 g008

Effect of Synthesis Temperature on the Size of ZnO Nanoparticles Derived from Pineapple Peel Extract and Antibacterial Activity of ZnO–Starch Nanocomposite Films
Abstract
1. Introduction
2. Materials and Methods
2.1. Raw Materials
2.2. Preparation of Pineapple Peel Extract
2.3. Preparation of ZnO NPs
2.4. Characterization ZnO NPs
2.5. Preparation of ZnO–Starch Nanocomposite Films
2.6. Antibacterial Activity Assay
3. Results and Discussion
3.1. Functional Analysis
3.2. XRD Analysis
3.3. EDX Analysis
3.4. FESEM and TEM Analyses
3.5. Antibacterial Activity
4. Conclusions
Supplementary Materials
Author Contributions
Funding
Acknowledgments
Conflicts of Interest
References
- Espitia, P.J.P.; Soares, N.F.F.; Coimbra, J.S.R.; de Andrade, N.J.; Cruz, R.S.; Medeiros, E.A.A. Zinc Oxide Nanoparticles: Synthesis, Antimicrobial Activity and Food Packaging Application. Food Bioprocess. Tech. 2012, 5, 1447–1464. [Google Scholar] [CrossRef]
- Jamdagni, P.; Khatri, P.; Rana, J.S. Green Synthesis of Zinc Oxide Nanoparticles using Flower Extract of Nyctanthes arbor-tristis and their Antifungal Activity. J. King Saud Univ. Sci. 2018, 30, 168–175. [Google Scholar] [CrossRef]
- Suresh, D.; Nethravathi, P.C.; Udayabhanu; Rajanaika, H.; Nagabhushana, H.; Sharma, S.C. Green Synthesis of Multifunctional Zinc Oxide (ZnO) Nanoparticles using Cassia fistula Plant Extract and their Photodegradative, Antioxidant and Antibacterial Activities. Mater. Sci. Semicond. Proc. 2015, 31, 446–454. [Google Scholar] [CrossRef]
- Wang, Z.L. Zinc Oxide Nanostructures: Growth, Properties and Application. J. Phys.-Condens. Mat. 2004, 6, 829–858. [Google Scholar] [CrossRef]
- Stoimenov, P.K.; Klinger, R.L.; Marchin, G.L.; Klabunde, K.J. Metal Oxide Nanoparticles as Bactericidal Agents. Langmuir 2002, 18, 6679–6686. [Google Scholar] [CrossRef]
- Kolodziejczak-Radzimska, A.; Jesionowski, T. Zinc Oxide from Synthesis to Application: A Review. Materials 2014, 7, 2833–2881. [Google Scholar] [CrossRef]
- Ma, J.; Zhu, W.; Tian, Y.; Wang, Z. Preparation of Zinc Oxide-Starch Nanocomposite and Its Application on Coatings. Nanoscale Res. Lett. 2016, 11, 1–9. [Google Scholar] [CrossRef]
- Mahamuni, P.P.; Patil, P.M.; Dhanavade, M.J.; Shadija, P.G.; Lokhande, A.C.; Bohara, R.A. Synthesis and Characterization of Zinc Oxide Nanoparticles by using Polyol Chemistry for Their Antimicrobial and Antibiofilm Activity. Biochem. Biophys. 2019, 17, 71–80. [Google Scholar] [CrossRef]
- Nithya, K.; Kalyanasundharam, S. Effect of Chemically Synthesis Compared to Biosynthesized ZnO nanoparticles using Aqueous Extract of C. halicacabum and Their Antibacterial Activity. OpenNano 2019, 4, 1–12. [Google Scholar] [CrossRef]
- Kumar, S.S.; Venkateswarlu, P.; Rao, V.R.; Rao, N.G. Synthesis, Characterization and Optical Properties of Zinc Oxide Nanoparticles. Int. Nano Lett. 2013, 3, 1–6. [Google Scholar] [CrossRef]
- Nafchi, A.M.; Nassiri, R.; Sheibani, S.; Ariffin, F.; Karim, A.A. Preparation and Characterization of Bionanocomposite Films Filled with Nanorod-rich Zinc Oxide. Carbohydr. Polym. 2013, 96, 233–239. [Google Scholar] [CrossRef] [PubMed]
- Prasad, V.; Shaikh, A.J.; Kath, A.A.; Bisoyi, D.K.; Verma, A.K.; Vigneshwaran, N. Functional Behaviour of Paper Coated with Zinc Oxide-Soluble Starch Nanocomposite. J. Mater. Process. Tech. 2010, 210, 1962–1967. [Google Scholar] [CrossRef]
- Yu, J.; Yang, J.; Liu, B.; Ma, X. Preparation and Characterization of Glycerol Plasticized-Pea Starch/ZnO-Carboxymethylcellulose Sodium Nanocomposite. Bioresour. Technol. 2009, 100, 2832–2841. [Google Scholar] [CrossRef] [PubMed]
- Espitia, P.J.P.; Soares, N.F.F.; Teofilo, R.; Coimbra, J.S.R.; Vitor, D.M.; Batista, R.A.; Ferreira, S.O.; de Andrade, N.J.; Medeiros, E.A.A. Physical-Mechanical and Antimicrobial Properties of Nanocomposite Films with Pediocin and ZnO Nanoparticles. Carbohydr. Polym. 2013, 94, 199–208. [Google Scholar] [CrossRef]
- Yadav, A.; Prasad, V.; Kathe, A.A.; Yadav, D.; Sundaramoorthy, C.; Vigneshwaran, N. Functional Finishing in Cotton Fabrics using Zinc Oxide Nanoparticle. Bull. Mater. Sci. 2006, 29, 641–645. [Google Scholar] [CrossRef]
- Trandafilovic, L.V.; Bozanic, D.K.; Dimitrijevic-Brankovic, S.; Luyt, A.S.; Drokovic, V. Fabrication and Antibacterial Properties ZnO-Alginate Nanocomposite. Carbohydr. Polym. 2012, 88, 263–269. [Google Scholar] [CrossRef]
- Vural, S.; Koytepe, S.; Seckin, T.; Adiguzel, I. Synthesis, Characterization UV and Dielectric Properties of Hexagonal Dislike ZnO Particles Embedded in Polyimides. Mater. Res. Bull. 2011, 46, 1679–1685. [Google Scholar] [CrossRef]
- Li, L.H.; Deng, J.C.; Deng, H.R.; Liu, Z.L.; Xin, L. Synthesis and Characterization of Chitosan/ZnO Nanoparticles Composite Membrane. Carbohydr. Res. 2010, 345, 994–998. [Google Scholar] [CrossRef]
- Warsiki, E.; Bawardi, J.T. Assessing Mechanical Properties and Antimicrobial Activity of Zinc Oxide-Starch Biofilm. IOP Conf. Ser: Earth Environ. Sci. 2018, 209, 1–6. [Google Scholar] [CrossRef]
- Rai, M.; Yadov, A.; Gade, A. Silver Nanoparticles as A New Generation of Antimicrobials. Biotechnol. Adv. 2009, 27, 76–83. [Google Scholar] [CrossRef]
- Poulose, S.; Panda, T.; Nair, P.P.; Theodore, T. Biosynthesis of Silver Nanoparticles. J. Nanosci. Nanotechnol. 2014, 14, 2038–2049. [Google Scholar] [CrossRef] [PubMed]
- de Simone, S.; Gallo, A.L.; Paladini, F.; Sannino, A.; Pollini, M. Development of Silver Nano-Coatings Silk Sutures as A Novel Approach Against Surgical Infection. J. Mater. Sci. Mater. Med. 2014, 25, 2205–2214. [Google Scholar] [CrossRef] [PubMed]
- Allahverdiyev, A.M.; Abamor, E.S.; Bagirova, M.; Rafailovich, M. Antimicrobial Effects of TiO2 and Ag2O Nanoparticles Against Drug Resistant Bacteria and Leishmania Parasites. Future Microbiol. 2011, 6, 933–940. [Google Scholar] [CrossRef] [PubMed]
- Hamal, A.M.; Haggstrom, J.A.; Marchin, G.L.; Ikenberry, A.; Hohn, K.; Klabunde, K.J. A Multifunctional Biocide/Sporocide and Photocatalyst Based on Titanium Oxide (TiO2) Codoped with Silver, Carbon and Sulfur. Langmuir 2010, 26, 2805–2810. [Google Scholar] [CrossRef] [PubMed]
- Blecher, K.; Nasir, A.; Friedman, A. The Growing Role of Nanotechnology in Combating Infectious Disease. Virulence 2011, 2, 395–401. [Google Scholar] [CrossRef] [PubMed]
- Palanikumar, L.; Ramasamy, S.N.; Balachandran, C. Size Dependent Antimicrobial Response of Zinc Oxide Nanoparticles. IET Nanobiotechnol. 2014, 8, 111–117. [Google Scholar] [CrossRef] [PubMed]
- Huh, A.J.; Kwon, Y.J. Nanoantibiotics: A New Paradigm for Treating Infectious Diseases using Nanomaterials in the Antibiotics Resistant Era. J. Control. Release 2011, 156, 128–145. [Google Scholar] [CrossRef]
- Dastjerdi, R.; Montazer, M. A Review on the Application of Inorganic Nano-Structured Materials in the Modification of Textiles Focus on Anti-microbial Properties. Colloids Surf. B Biointerfaces 2010, 79, 5–18. [Google Scholar] [CrossRef]
- Anghel, A.G.; Grumezescu, A.M.; Chirea, M.; Grumezescu, V.; Socol, G.; Iordache, F.; Oprea, A.E.; Anghel, I.; Holban, A.M. MAPLE Fabricated Fe3O4@Cinnamomum Verum Antimicrobial Surfaces for Improved Gastrostomy Tubes. Molecules 2014, 19, 8981–8994. [Google Scholar] [CrossRef]
- Ren, G.; Hu, D.; Cheng, E.W.C.; Vargas-Reus, M.A.; Reip, P.; Allaker, R.P. Characterisation of Copper Oxide Nanoparticles for Antimicrobial Applications. Int. J. Antimicrob. Agents 2009, 33, 587–590. [Google Scholar] [CrossRef]
- Hans, M.; Erbe, A.; Mathews, S.; Chen, Y.; Solioz, M.; Mucklich, F. Role of Copper Oxides in Contact Killing of Bacteria. Langmuir 2013, 29, 16160–16166. [Google Scholar] [CrossRef] [PubMed]
- Pelgrift, R.Y.; Friedman, A.J. Nanotechnology as A Therapeutic Tool to Combat Microbial Resistance”. Adv. Drug Deliv. Rev. 2013, 65, 1803–1815. [Google Scholar] [CrossRef] [PubMed]
- Lellouche, J.; Friedman, A.; Lellouche, J.P.; Gedanken, A.; Banin, E. Improved Antibacterial and Antibiofilm Activity of Magnesium Fluoride Nanoparticles obtained by Water-Based Ultrasound Chemistry. Nanomed. Nanotechnol. 2012, 8, 702–711. [Google Scholar] [CrossRef] [PubMed]
- Carpenter, A.W.; Schoenfisch, M.H. Nitric Oxide Release: Part II. Therapeutic Applications. Chem. Soc. Rev. 2012, 41, 3742–3752. [Google Scholar] [CrossRef] [PubMed]
- Kutner, A.J.; Friedman, A.J. Use of Nitric Oxide Nanoparticulate Platform for the Treatment of Skin and Soft Tissue Infections. Wiley Interdiscip. Rev. Nanomed. Nanobiotechnol. 2013, 5, 502–514. [Google Scholar] [CrossRef] [PubMed]
- Ansari, M.A.; Khan, H.M.; Khan, A.A.; Cameotra, S.S.; Saquib, Q.; Musarrat, J. Interaction of Al2O3 Nanoparticles with Escherichia coli and their Cell Envelope Biomolecules. J. Appl. Microbiol. 2014, 116, 772–783. [Google Scholar] [CrossRef]
- Azam, A.; Ahmed, A.S.; Oves, M.; Khan, M.S.; Memic, A. Size Dependent Antimicrobial Properties of CuO Nanoparricles against Gram-positive and Negative bacterial Strains. Int. J. Nanomed. 2012, 7, 3527–3535. [Google Scholar] [CrossRef]
- Jadhav, S.; Gaikwad, S.; Nimse, M.; Rajbhoj, A. Copper Oxide Nanoparticles: Synthesis, Characterization, and their Antibacterial Activity. J. Clust. Sci. 2011, 22, 121–129. [Google Scholar] [CrossRef]
- Peters, R.J.B.; Bouwmeester, H.; Gottardo, S.; Amenta, V.; Arena, M.; Brondhoff, P.; Marvin, H.J.P.; Mech, A.; Moniz, F.B.; Pesudo, L.Q.; et al. Nanomaterials for Products and Application in Agriculture Feed and Food. Trends Food Sci. Technol. 2016, 54, 155–164. [Google Scholar] [CrossRef]
- Singh, P.K.; Jairath, G.; Ahlawat, S.S. Nanotechnology: A Future Tool to Improve Quality and Safety in Meat Industry. Int. J. Food Sci. Tech. 2016, 53, 1739–1749. [Google Scholar] [CrossRef]
- Wagner, G.; Korenkov, V.; Judy, J.D.; Bertsch, P.M. Nanoparticles Composed of Zn and ZnO Inhibit Peronospora Tabacina Spore Germination In Vitro and P. tabacina Infectivity on Tabacco Leaves. Nanomaterials 2016, 6, 50. [Google Scholar] [CrossRef] [PubMed]
- Xie, Y.; He, Y.; Irwin, P.L.; Jin, T.; Shi, X. Antibacterial Activity and Mechanism of Action of Zinc Oxide Nanoparticles Against Compylobacter Jejuni. Appl. Environ. Microbiol. 2011, 77, 2325–2331. [Google Scholar] [CrossRef] [PubMed]
- Uzzaman, S.; Ali, A.; Asif, M.; Mashrai, A.; Khanam, H. Green Synthesis of ZnO Nanoparticles using Bacillus subtilis and their Catalytic Performance in the One-Pot Synthesis of Steroidal Thiophenes. Eur. Chem. Bull. 2014, 3, 939–945. [Google Scholar]
- Ahmed, S.; Ahmad, M.; Swami, B.L.; Ikram, S. A Review on Plants Extract Mediated Synthesis of Silver Nanoparticles for Antimicrobial Application: A Green Expertise. J. Adv. Res. 2016, 7, 17–28. [Google Scholar] [CrossRef] [PubMed]
- Jafarirad, S.; Mehrabi, M.; Divband, B.; Kosari-Nasab, M. Biofabrication of Zinc Oxide Nanoparticles using Fruit Extract of Rosa canina and their Toxic Potential Against Bacteria: A Mechanistic Approach. Mater. Sci. Eng. C 2016, 59, 296–302. [Google Scholar] [CrossRef] [PubMed]
- Sangeetha, G.; Rajeshwari, S.; Venckatesh, R. Green Synthesis of Zinc Oxide Nanoparticles by Aloe barbadensis miller leaf extract: Structure and Optical Properties. Mater. Res. Bull. 2011, 46, 2560–2566. [Google Scholar] [CrossRef]
- Dobrucka, R.; Długaszewska, J. Biosynthesis and Antibacterial Activity of ZnO Nanoparticles using Trifolium pratense Flower Extract. Saudi J. Biol. Sci. 2016, 23, 517–523. [Google Scholar] [CrossRef]
- Devi, R.S.; Gayathri, R. Green Synthesis of Zinc Oxide Nanoparticles by using Hibiscus rosa-sinensis. Int. J. Curr. Eng. Technol. 2014, 4, 2444–2446. [Google Scholar]
- Oudhia, A.; Kulkarni, P.; Sharma, S. Green Synthesis of ZnO Nanotubes for Bioapplications. Int. J. Curr. Eng. Technol. 2015, 1, 280–281. [Google Scholar]
- Qu, J.; Yuan, X.; Wang, X.; Shao, P. Zinc Accumulation and Synthesis of ZnO Nanoparticles using Physalis alkekengi L. Environ. Pollut. 2011, 159, 1783–1788. [Google Scholar] [CrossRef]
- Senthilkumar, S.R.; Sivakumar, T. Green Tea Camellia sinensis Mediated Synthesis of Zinc Oxide Nanoparticles and Studies on their Antimicrobial Activities. Int. J. Pharm. Pharm. Sci. 2014, 6, 461–465. [Google Scholar]
- Darroudi, M.; Sabouri, Z.; Oskuee, R.K.; Zak, A.K.; Kargar, H.; Hamid, M.H.N.A. Sol-Gel Synthesis, Characterization and Neurotoxicity Effect of Zinc Oxide Nanoparticles using Gum Tagacanth. Ceramics Int. 2013, 40, 4827–4831. [Google Scholar] [CrossRef]
- Khan, S.A.; Noreen, F.; Kanwal, S.; Iqbal, A.; Hussain, G. Green Synthesis of ZnO and Cu-Doped ZnO Nanoparticles from Leaf Extracts of Abutilon indicum, Clerodendrum infortunatum, Clerodendrum inerme and Investigation of their Biological and Photocatalytic Activities. Mater. Sci. Eng. C 2018, 82, 46–59. [Google Scholar] [CrossRef] [PubMed]
- Saranya, S.; Eswari, A.; Gayathri, E.; Eswari, S.; Vijayarani, K. Green Synthesis of Metallic Nanoparticles using Aqueous Plant Extract and their Antibacterial Activity. Int. J. Curr. Microbiol. Appl. Sci. 2017, 6, 1834–1845. [Google Scholar] [CrossRef]
- Hoseinpour, V.; Souri, M.; Ghaemi, N.; Shakeri, A. Optimization of Green Synthesis of ZnO Nanoparticles by Dittrichia graveolens (L.) Aqueous Extract. Health Biotechnol. Biopharm. J. 2017, 1, 39–49. [Google Scholar]
- Kokila, T.; Ramesh, P.S.; Geetha, D. Biosynthesis of Silver Nanoparticles from Cavendish Banana Peel Extract and its Antibacterial and Free Radical Scavenging Assay: A Novel Biological Approach. Appl. Nanosci. 2015, 5, 911–920. [Google Scholar] [CrossRef]
- Siregar, T.M.; Cahyana, A.H.; Gunawan, R.J. Characteristics and Free Radical Scavenging Activity of Zinc Oxide (ZnO) Nanoparticles Derived from Extract of Coriander (Coriandrum sativum L.). Reaktor. Chem. Eng. J. 2017, 17, 144–150. [Google Scholar] [CrossRef][Green Version]
- Ibrahim, H.M.M. Green Synthesis and Characterization of Silver Nanoparticles using Banana Peel Extract and their Antimicrobial Activity against Representative Microorganisms. J. Radiat. Res. Appl. Sci. 2015, 8, 265–275. [Google Scholar] [CrossRef]
- Kaviya, S.; Santhanalakshmi, J.; Viswanathan, B.; Muthumary, J.; Srinivasan, K. Biosynthesis of Silver Nanoparticles using Citrus sinensis Peel Extract and its Antibacterial Activity. Spectrochim. Acta A Mol. Biomol. Spectrosc. 2011, 79, 594–598. [Google Scholar] [CrossRef]
- Jayarajan, M.; Arunachalam, R.; Annadurai, G. Agricultural Waste of Jackfruit Peel Nano-Porous Adsorbent for Removal of Rhodamine Dye. Asian J. Appl. Sci. 2011, 4, 263–270. [Google Scholar]
- Nisha, S.N.; Aysha, O.S.; Rahaman, J.S.N.; Kumar, P.V.; Valli, S.; Nirmala, P.; Reena, A. Lemon Peels Mediated Synthesis of Silver Nanoparticles and its Antidermatophytic Activity. Spectrochim. Acta A Mol. Biomol. Spectrosc. 2014, 124, 194–198. [Google Scholar] [CrossRef] [PubMed]
- Yang, N.; Li, W.H. Mango Peel Extract Mediated Novel Route for Synthesis of Silver Nanoparticles and Antibacterial A of Silver Nanoparticles Loaded onto Non-Woven Fabrics. Ind. Crops Prod. 2013, 48, 81–88. [Google Scholar] [CrossRef]
- Bankar, A.V.; Joshi, B.C.; Kumar, A.R.; Zinjarde, S. Banana Peel Extract Mediated Novel Route for the Synthesis of Silver Nanoparticles. Colloids Surf. A 2010, 368, 58–63. [Google Scholar] [CrossRef]
- Thilagavathi, T.; Renuka, R.; Ravi, S.P. Bio-Synthesis of Silver Nanoparticles using Punica granatum (pomegranate) Peel Extract: A Novel Approach towards Waste Utilization. Int. J. Adv. Sci. Eng. Inform. Technol. 2016, 3, 234–236. [Google Scholar]
- Alzahrani, E. Eco-Friendly Production of Silver Nanoparticles from Peel of Tangerine for Degradation of Dye. World J. Nano Sci. Eng. 2015, 5, 10–16. [Google Scholar] [CrossRef][Green Version]
- Sukri, S.N.A.M.; Shameli, K.; Wong, M.M.T.; Teow, S.Y.; Chew, J.; Ismail, N.A. Cytotoxicity and Antibacterial Activities of Plant-Mediated Synthesized Zinc Oxide (ZnO) Nanoparticles using Punica granatum (pomegranate) Fruit Peel Extract. J. Mol. Struct. 2019, 1189, 57–65. [Google Scholar] [CrossRef]
- Aminuzzaman, M.; Ying, L.P.; Goh, W.S.; Watanabe, A. Green Synthesis of Zinc Oxide Nanoparticles using Aqueous Extract of Garcinia mangostana Fruit Pericarp and their Photocatalytic Activity. Bull. Mater. Sci. 2018, 41, 1–10. [Google Scholar] [CrossRef]
- Ramesh, P.; Rajendran, A.; Subramanian, A. Synthesis of Zinc Oxide Nanoparticles from Fruit of Citrus aurantifolia by Chemical and Green Method. Asian J. Phytomed. Clin. Res. 2014, 2, 189–195. [Google Scholar]
- Karnan, T.; Selvakuamr, S.A.S. Biosynthesis of ZnO Nanoparticles using Rambutan (Nephelium lappaceumL.) Peel Extract and their Photocatalytic Activity on Methyl Orange Dye. J. Mol. Struct. 2016, 1125, 358–365. [Google Scholar] [CrossRef]
- Shamsudin, R.; Daud, W.R.W.; Takriff, M.S.; Hassan, O. Physicochemical Properties of the Josapine Variety of Pineapple Fruit. Int. J. Food Eng. 2007, 3, 1–12. [Google Scholar] [CrossRef]
- Norshazila, S.; Zahir, I.S.; Suleiman, K.M.; Aisyah, M.R.; Kamarudin, K.R. Antioxidant Levels and Activities of Selected Seeds of Malaysian Tropical Fruits. Malays. J. Nutr. 2010, 16, 149–159. [Google Scholar] [PubMed]
- Alebooyeh, R.; Nafchi, A.M.; Jokar, M. The Effects of ZnO Nanorods on the Characteristics of Sago Starch Biodegradable Films. J. Chem. Health Risks 2012, 2, 13–16. [Google Scholar]
- Abdorreza, M.N.; Cheng, L.H.; Karim, A.A. Effects of Plasticizers on Thermal Properties and Heat Sealability of Sago Starch Films. Food Hydrocolloids 2011, 25, 56–60. [Google Scholar] [CrossRef]
- Xu, Y.X.; Kim, K.M.; Hanna, M.A.; Nag, D. Chitosan-Starch Composite Film: Preparation and Characterization. Ind. Crops Prod. 2005, 21, 185–192. [Google Scholar] [CrossRef]
- Matinise, N.; Fuku, X.G.; Kaviyarasu, K.; Mayedwa, N.; Maaza, M. ZnO Nanoparticles via Moringa oleifera Green Synthesis: Physical Properties & Mechanism of Formation. Appl. Surf. Sci. 2017, 406, 339–347. [Google Scholar]
- Ramesh, M.; Anbuvannan, M.; Viruthagiri, G. Green Synthesis of ZnO Nanoparticles using Solanum nigrum Leaf Extract and their Antibacterial Activity. Spectrochim. Acta A Mol. Biomol. Spectrosc. 2015, 136, 864–870. [Google Scholar] [CrossRef]
- Sathyavathi, R.; Krishna, M.B.; Rao, S.V.; Saritha, R.; Rao, D.N. Biosynthesis of Silver Nanoparticles using Coriandrum satium Leaf Extract and their Application in Nonlinear Optics. Adv. Sci. Lett. 2010, 3, 1–6. [Google Scholar] [CrossRef]
- Kumar, H.; Rani, R. Structural and Optical Characterization of ZnO Nanoparticles Synthesized by Microemulsion Route. Int. Lett. Chem. Phys. Astronomy 2013, 19, 26–36. [Google Scholar] [CrossRef]
- Talam, S.; Karumuri, S.R.; Gunnam, N. Synthesis, Characterization, and Spectroscopic Properties of ZnO Nanoparticles. Int. Scholarly Res. Notices Nanotechnol. 2012, 2012, 1–6. [Google Scholar] [CrossRef]
- Kumar, K.M.; Mandal, B.M.; Naidu, E.A.; Sinha, M.; Kumar, K.S.; Reddy, P.S. Synthesis and Characterization of Flower Shaped Zinc Oxide Nanostructure and its Antimicrobial Activity. Spectrochim. Acta A Mol. Biomol. Spectrosc. 2013, 104, 171–174. [Google Scholar] [CrossRef]
- Shaziman, S.; Ismailrosdi, A.S.; Mamat, M.; Zoolfakar, A.S. Influence of Growth Time and Temperature on the Morphology of ZnO Nanorods via Hydrothermal. IOP Conf. Series Mater. Sci. Eng. 2015, 99, 1–8. [Google Scholar] [CrossRef]
- Hajipour, M.J.; Fromm, K.; Ashkarran, A.A.; de Aberasturi, D.J.; de Larramendi, I.R.; Rojo, T.; Serpooshen, V.; Parak, W.J.; Mahmoudi, M. Antibacterial Properties of Nanoparticles. Trends Biotechnol. 2012, 30, 499–511. [Google Scholar] [CrossRef] [PubMed]
- Tayel, A.A.; El-Tras, W.; Moussa, S.; El-Baz, A.; Mahrous, H.; Salem, M.F.; Brimer, L. Antibacterial Action of Zinc Oxide Nanoparticles against Foodborne Pathogens. J. Food Safety 2011, 31, 211–218. [Google Scholar] [CrossRef]
- Kaimlová, M.; Nemogová, I.; Kolářová, K.; Slepička, P.; Švorčík, V.; Siegel, J. Optimization of Silver Nanowire Formation on Laser Processed PEN: Surface Properties and Antibacterial Effects. Appl. Surf. Sci. 2019, 473, 516–526. [Google Scholar] [CrossRef]
- Polívková, M.; Valová, M.; Siegela, J.; Rimpelováb, S.; Hubáčekc, T.; Lyutakova, O.; Švorčíka, V. Antibacterial Properties of Palladium Nanostructures Sputtered on Polyethylene Naphthalate. RSC Adv. 2015, 90, 1–19. [Google Scholar] [CrossRef]

| Wavenumbers | Heating (60 °C) | Non-Heating (28 °C) | Peak Assignment | Reference | |
|---|---|---|---|---|---|
| 3330–3120 | + | + | O–H stretching band | [77] | |
| 2340 | + | C–H stretching | [77] | ||
| 1640–1610 | + | + | C=O functional group | [2] | |
| 1480–1470 | + | + | Amine NH vibration stretch | [2] | |
| 1440–1380 | + | + | CH3 bending | [68] | |
| 872–866 | + | + | Absorption band of ZnO | [76] | |
| 701–654 | + | + | |||
| Concentration of ZnO NPs in Starch Films | Zone of Inhibition (mm) | ||||||||
|---|---|---|---|---|---|---|---|---|---|
| Bacillus subtilis UPMC 1175 | Salmonella enterica serotype Choleraesuis | ||||||||
| i | ii | iii | Mean | i | ii | iii | Mean | ||
| Nonheated (28 °C) | 0% | Inhibition Zone Diameter | No Inhibition Zone | ||||||
| 1% | 11 | 9 | 9 | 9.67 | |||||
| 3% | 15 | 15 | 15 | 15.00 | |||||
| 5% | 12 | 13 | 12 | 12.33 | |||||
| Heated (60 °C) | 1% | 9 | 9 | 8 | 8.67 | ||||
| 3% | 13 | 13 | 14 | 13.33 | |||||
| 5% | 10 | 11 | 12 | 11.00 | |||||
© 2020 by the authors. Licensee MDPI, Basel, Switzerland. This article is an open access article distributed under the terms and conditions of the Creative Commons Attribution (CC BY) license (http://creativecommons.org/licenses/by/4.0/).
Share and Cite
Hassan Basri, H.; Talib, R.A.; Sukor, R.; Othman, S.H.; Ariffin, H. Effect of Synthesis Temperature on the Size of ZnO Nanoparticles Derived from Pineapple Peel Extract and Antibacterial Activity of ZnO–Starch Nanocomposite Films. Nanomaterials 2020, 10, 1061. https://doi.org/10.3390/nano10061061
Hassan Basri H, Talib RA, Sukor R, Othman SH, Ariffin H. Effect of Synthesis Temperature on the Size of ZnO Nanoparticles Derived from Pineapple Peel Extract and Antibacterial Activity of ZnO–Starch Nanocomposite Films. Nanomaterials. 2020; 10(6):1061. https://doi.org/10.3390/nano10061061
Chicago/Turabian StyleHassan Basri, Hasbullah, Rosnita A. Talib, Rashidah Sukor, Siti Hajar Othman, and Hidayah Ariffin. 2020. "Effect of Synthesis Temperature on the Size of ZnO Nanoparticles Derived from Pineapple Peel Extract and Antibacterial Activity of ZnO–Starch Nanocomposite Films" Nanomaterials 10, no. 6: 1061. https://doi.org/10.3390/nano10061061
APA StyleHassan Basri, H., Talib, R. A., Sukor, R., Othman, S. H., & Ariffin, H. (2020). Effect of Synthesis Temperature on the Size of ZnO Nanoparticles Derived from Pineapple Peel Extract and Antibacterial Activity of ZnO–Starch Nanocomposite Films. Nanomaterials, 10(6), 1061. https://doi.org/10.3390/nano10061061

